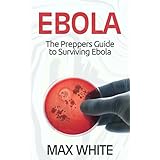

A TEXAS NURSE WHO ATTENDED AN EBOLA PATIENT IS NOW ISOLATED ABOARD A CRUISE SHIP
 PD
PDAccording to the U.S. State Department A Texas health care worker who may have had contact with specimens from the first patient diagnosed with Ebola in the U.S. has been isolated on a cruise ship despite showing no symptoms of the disease. The State Department released their statement on Friday October 17, 2014. The Texas Health Presbyterian Hospital worker, did not have direct contact with now deceased Liberian patient, Thomas Eric Duncan. However, it is thought that she may have lab processed some of his bodily fluids about 19 days ago. The incubation period for Ebola is thought to be 21 days. The health care worker left on a cruise from Galveston on Sunday, State Department spokeswoman Jen Psaki said on Friday. The worker had not completed any where near the 21 day recommended self monitoring period when she embarked on the cruise but apparently did not knowingly violate any protocols. She has been self-monitoring since last Monday and has yet to develop a fever or show any other symptom of Ebola, the State Department news release indicated. The worker and a traveling companion voluntarily isolated themselves in their cabin. U.S. officials are attempting to arrange for the ship to return to the country. Of course there is a problem, like most ocean cruise ships the ship is not under American registry, so the United states has virtually no jurisdiction over it while out of port. .
The employee has been self-monitoring since last Monday and has yet to develop a fever or show any other symptom of Ebola, the statement said. The worker and a companion voluntarily isolated themselves in their cabin, and U.S. officials are arranging for the ship to return to the country.At least one port of call on the cruise ship's itinerary has refused entry for the ship because of the Ebola threat. It is thought that tomorrow will mark 21 days since last suspected potential exposure.
The United States has had so far one death from Ebola, one actual Ebola infection contracted in the U.S. and has about 1,000 individuals now under formal monitoring due to known contacts. That compares to zero Ebola issues in the European nations that simply banned flights from Ebola stricken nations. A proper Ebola protocol in our opinion would involve doctors, nurses and other health care workers living in a contained isolation ward complete with living quarters for the medical staff on 30 day shifts, followed by 21 day stays in a separate isolation quarter before being released back to home and resumption of ordinary duties. Obviously such a protocol would not allow for the handling of hundreds or thousands of ebola patients. Yet the Obama administration insists on continuing flights, admitting ebola patients, and sending troops by the thousands to the ebola afflicted nations presenting us with yet another massive isolation and surveillance task. The Obama administration had already committed to flight continuance, patient admittance and troops to the infected zone before the so far basically tentative protocols were in place. In the case of the health worker who proceeded on her pre-planned cruise on schedule she left the country before being notified of the U.S. Centers for Disease Control and Prevention's (CDC) updated requirement for active monitoring, the statement said.later experience may teach us that a 21 day isolation / observation period is not long enough. The common sense thing to do is to stop the flights, prepare special camps for our returning troops and bring them back ASAP, in short slow the flow of ebola patients and monitoring / isolation candidates. We have only a very ,limited capacity for such patients and it is badly strained already. This is what would be done if Washington had any adult leadership. We become used to lunacy among the DC elite ruling class of late, but it is past time to ask if in fact, what we are seeing is deadly treason?

0 komentar:
Posting Komentar